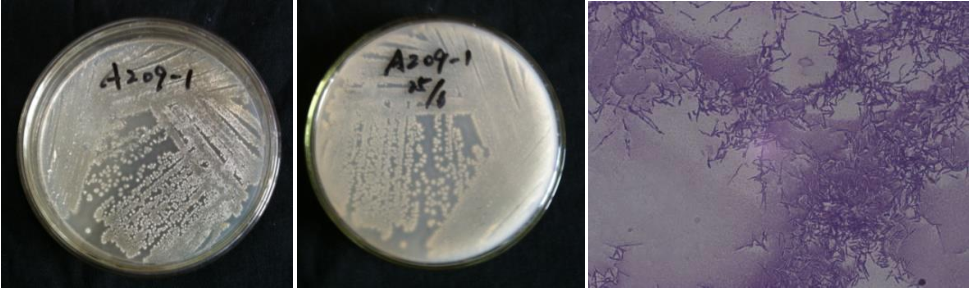

Loading...
| StrainNO | A209 |
| Classification | Actinomadura |
| 16s rDNA sequence | GAGTTTGATCCTGGCTCAGGACGAACGCTGGCGGCGTGCTTAACACATGCAAGTCGAGCGGAAAGGCCCTTCGGGGTACTCGAG CGGCGAACGGGTGAGTAACACGTGAGTAACCTGCCCTTGGCTCTGGGATAAGCCCGGGAAACTGGGTCTAATACCGGATATGAC CATCTCACGCATGTGATGGTGGTGGAAAGTTTTTCGGCTGGGGATGGGCTCGCGGCCTATCAGCTTGTTGGTGGGGTAGTGGCC TACCAAGGCGACGACGGGTAGCCGGCCTGAGAGGGCGACCGGCCACACTGGGACTGAGACACGGCCCAGACTCCTACGGGAGGC AGCAGTGGGGAATATTGCACAATGGGCGGAAGCCTGATGCAGCGACGCCGCGTGGGGGATGAAGGCCTTCGGGTTGTAAACCTC TTTCAGCACCGACGAAGGTGACGGTAGGTGCAGAAGAAGCGCCGGCTAACTACGTGCCAGCAGCCGCGGTAATACGTAGGGCGC AAGCGTTGTCCGGAATTATTGGGCGTAAAGAGCTCGTAGGCGGTTTGTCGCGTCTGTCGTGAAAGCTCGCAGCTTAACTGCGGG TCTGCGGTGGATACGGGCAGGCTAGAGGCAGGTAGGGGAGAACGGAATTCCCGGTGTAGCGGTGAAATGCGCAGATATCGGGAG GAACACCGGTGGCGAAGGCGGTTCTCTGGGCCTGTACTGACGCTGAGGAGCGAAAGCGTGGGGAGCGAACAGGATTAGATACCC TGGTAGTCCACGCCGTAAACGTTGGGCGCTAGGTGTGGGGTTCTTCCACGGATTCCGCGCCGTAGCTAACGCATTAAGCGCCCC GCCTGGGGAGTACGGCCGCAAGGCTAAAACTCAAAGGAATTGACGGGGGCCCGCACAAGCGGCGGAGCATGTTGCTTAATTCGA CGCAACGCGAAGAACCTTACCAAGGCTTGACATCACCCGAAAACCGGCGGAGACGTCGGGTCCTTTTGGGCGGGTGACAGGTGG TGCATGGCTGTCGTCAGCTCGTGTCGTGAGATGTTGGGTTAAGTCCCGCAACGAGCGCAACCCTCGTTCCATGTTGCCAGCACG TTATGGTGGGGACTCATGGGAGACTGCCGGGGTCAACTCGGAGGAAGGTGGGGATGACGTCAAGTCATCATGCCCCTTATGTCTTGGGCTGCAAACATGCTACAATGGCCGGTACAGAGGGCTGCGATACCGCGAGGTGGAGCGAATCCCTAAAAGCCGGTCTCAGTT CGGATTGGGGTCTGCAACTCGACCCCATGAAGTCGGAGTCGCTAGTAATCGCAGATCAGCAACGCTGCGGTGAATACGTTCCCG GGCCTTGTACACACCGCCCGTCACGTCACGAAAGTCGGCAACACCCGAAGCCCGTGGCCCAACCCGTGAGGGGGGGAGCGGTCG AAGGTGGGGCCGGCGATTGGGACGAAGTCGTAACAAGGTA |
| Strain Morphology Photos | |
| Morphological Description | hyphae:branched;separated without breaking;broken into short branches;and 1 or 2 larger round spores;filaments:short;spore pile:bare;front:lime-white;back:soy juice yellow |